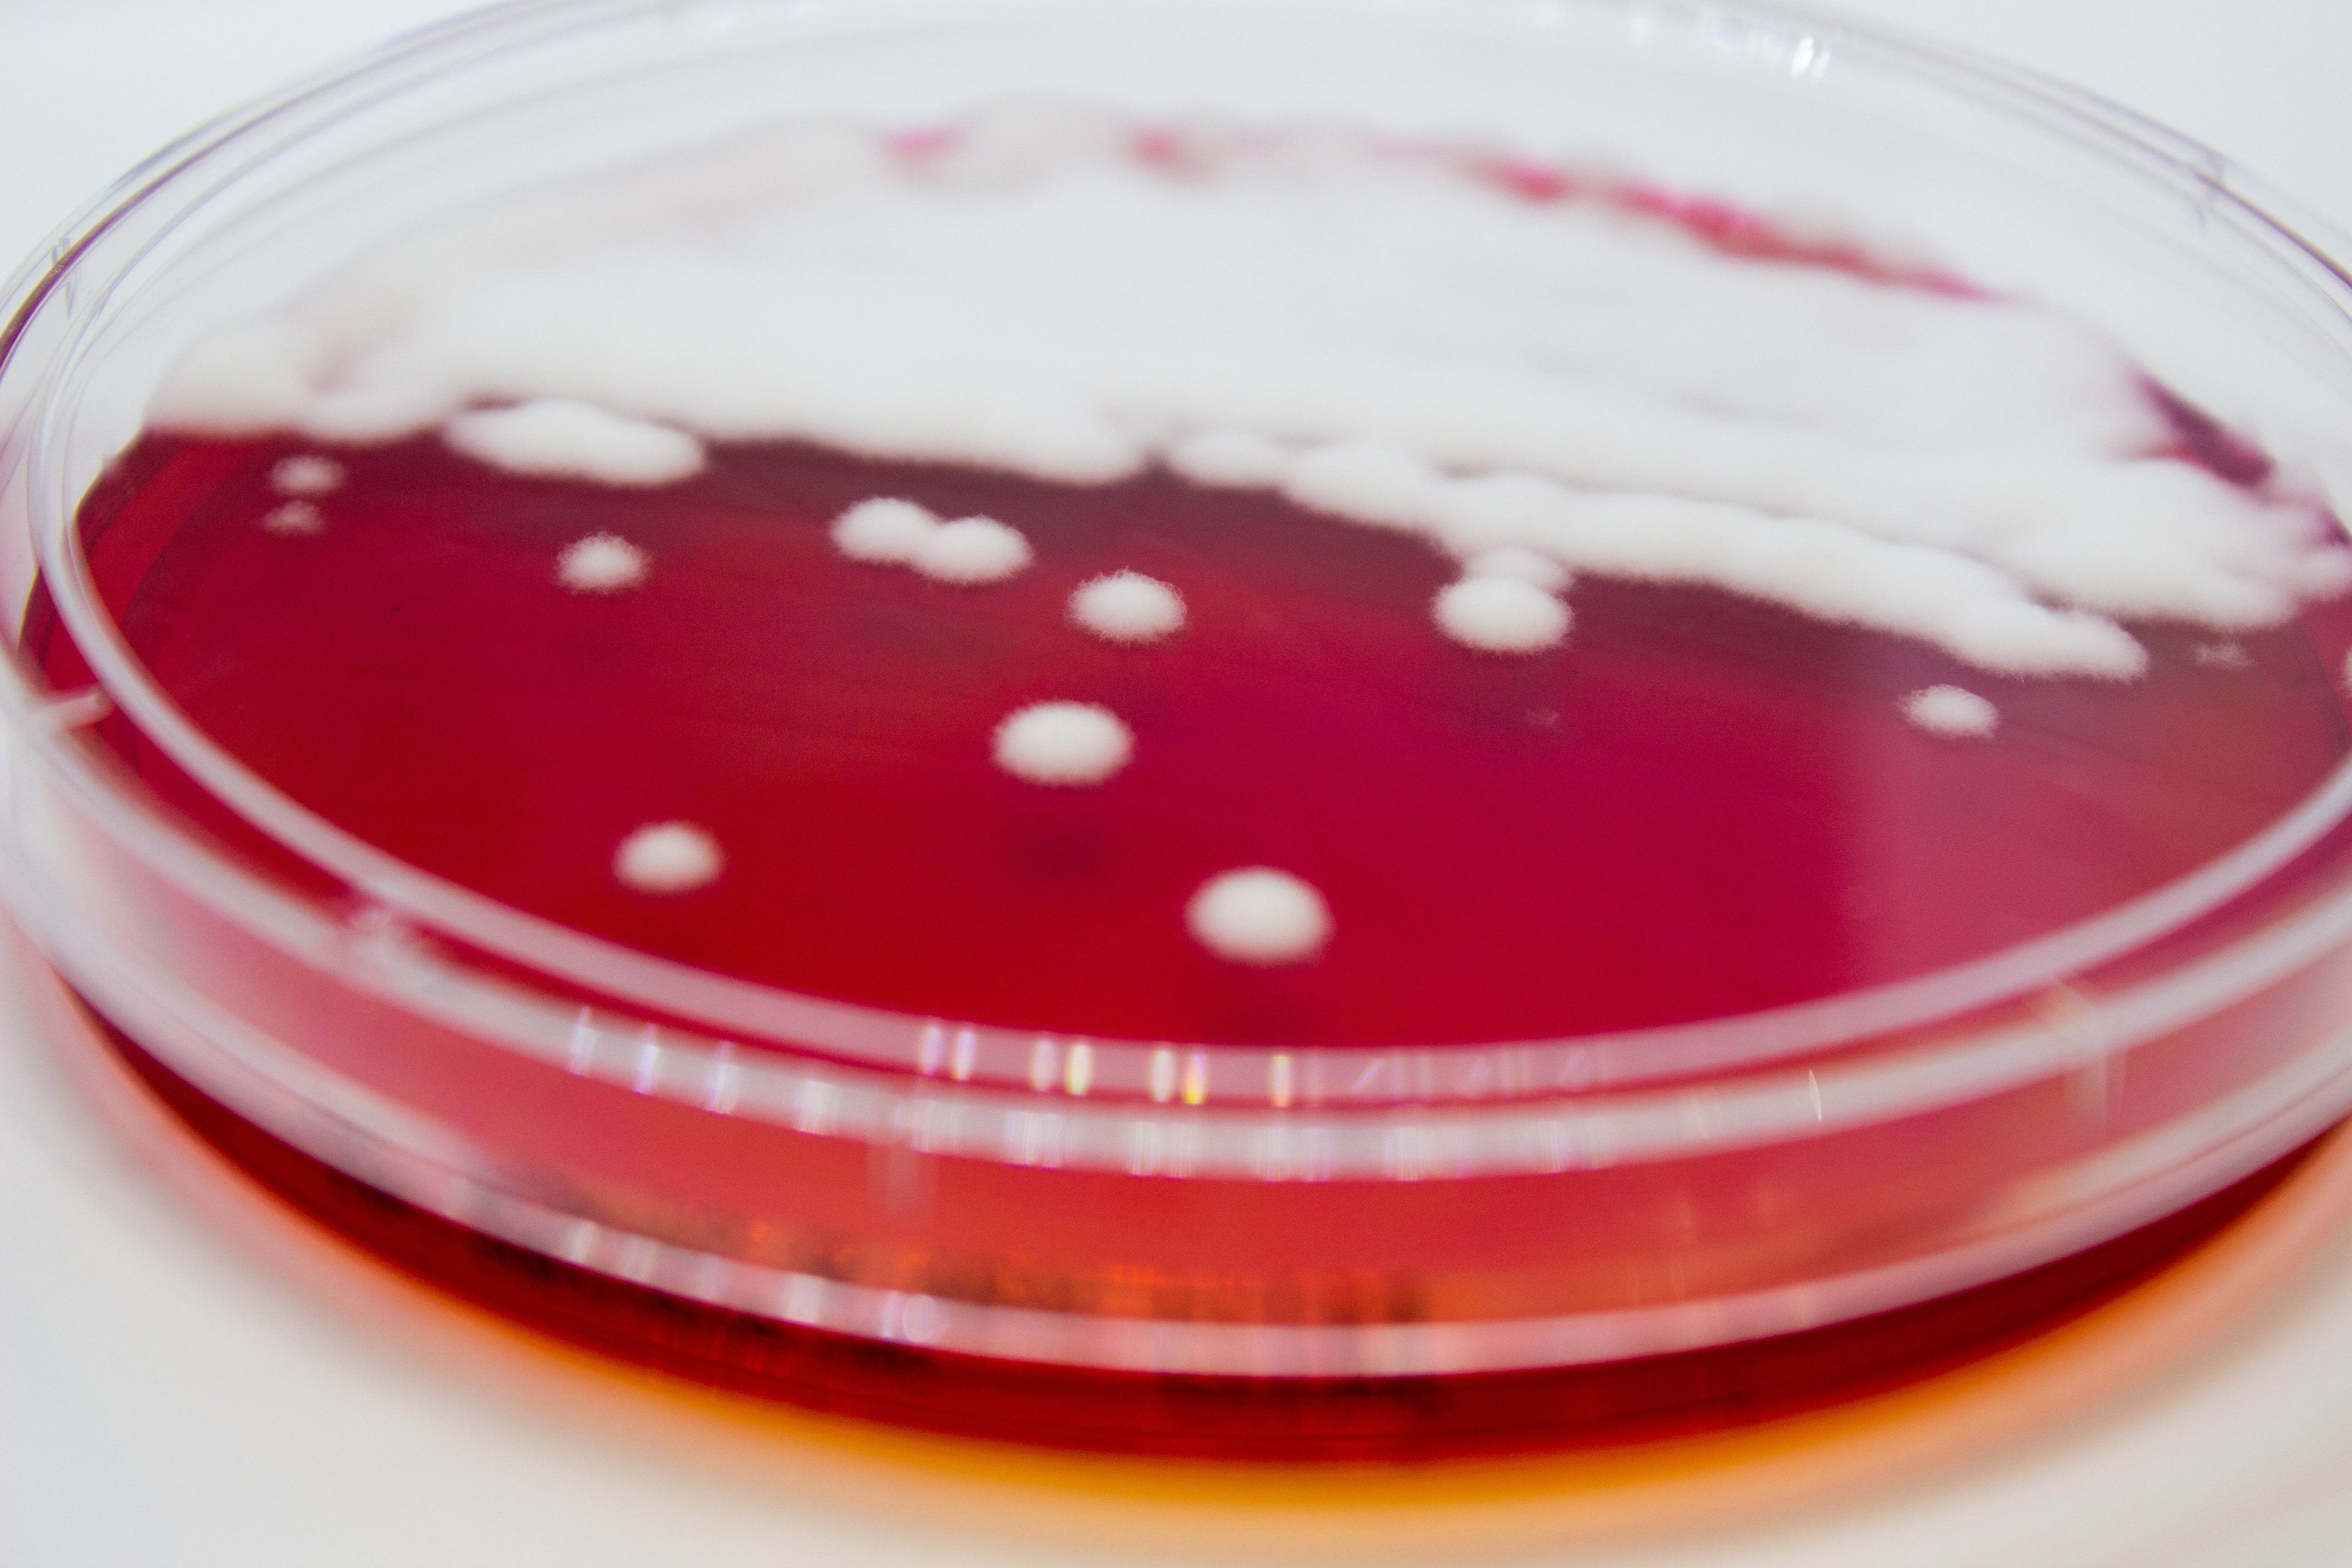

Description
500 g
This is a selective medium for selective isolation of dermatophytic fungi. Disclaimer: This product is for laboratory use only.Payment & Security
Your payment information is processed securely. We do not store credit card details nor have access to your credit card information.